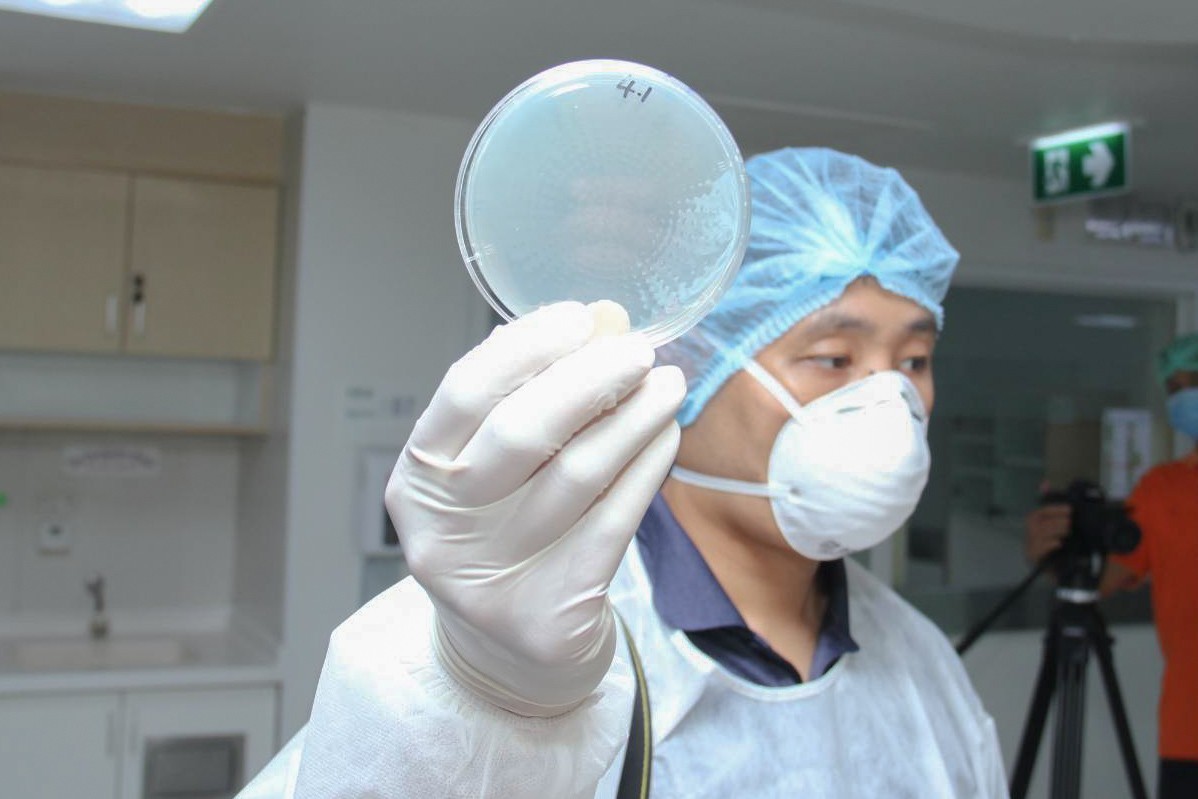

กระทรวงการอุดมศึกษา วิทยาศาสตร์ วิจัยและนวัตกรรม โดย สถาบันวิจัยวิทยาศาสตร์และเทคโนโลยีแห่งประเทศไทย (วว.) นำความเชี่ยวชาญด้านวิทยาศาสตร์ เทคโนโลยี นวัตกรรม ร่วมทดสอบห้องสำหรับดูแลผู้ป่วยที่เรียกว่า ห้องความดันลบ (Negative pressure) สำหรับแยกผู้ป่วยแพร่เชื้อทางอากาศ (Airborne Infection Isolation Room - AIIR) ณ โรงพยาบาลศิริราช เพื่อป้องกันการแพร่กระจายเชื้อจากผู้ป่วยออกไปสู่บริเวณอื่นในสถานพยาบาล
ดร.ชุติมา เอี่ยมโชติชวลิต ผู้ว่าการ วว. กล่าวว่า วว. ได้รับมอบหมายจาก ดร.สุวิทย์ เมษินทรีย์ รัฐมนตรีว่าการกระทรวงการอุดมศึกษา วิทยาศาสตร์ วิจัยและนวัตกรรม ให้เข้าร่วมทดสอบ “ห้องความดันลบ” เพื่อสร้างความเชื่อมั่นในการปรับปรุงห้องผู้ป่วยของโรงพยาบาลศิริราช ให้เป็นห้องสำหรับแยกผู้ป่วยแพร่เชื้อทางอากาศ ใช้ในการรองรับผู้ป่วยในสถานการณ์การแพร่ระบาดของโรคติดเชื้อโคโรน่าไวรัส 2019 ควบคุมการแพร่กระจายของเชื้อหรือการติดเชื้อในโรงพยาบาล โอกาสนี้ วว. ได้นำความเชี่ยวชาญด้านวิทยาศาสตร์ เทคโนโลยี และนวัตกรรม ของ 3 หน่วยงานภายใต้สังกัดของ วว. เข้าไปทดสอบห้องผู้ป่วยดังกล่าว ได้แก่ ศูนย์ความหลากหลายทางชีวภาพ ศูนย์ทดสอบและมาตรวิทยา ศูนย์พัฒนาและวิเคราะห์สมบัติของวัสดุ โดยมีกรอบการดำเนินงานทดสอบ ดังนี้

ศูนย์ความหลากหลายชีวภาพ มีภารกิจให้บริการด้านงานวิจัยพัฒนาและวิเคราะห์ทดสอบด้านจุลชีววิทยาให้กับหน่วยงานของรัฐและผู้ประกอบการ ดำเนินการตรวจสอบคุณภาพอากาศเพื่อหาปริมาณเชื้อจุลินทรีย์จากตัวอย่างอากาศ ตามวิธีทดสอบมาตรฐาน ISO 14698


ศูนย์ทดสอบและมาตรวิทยา วว. มีภารกิจให้บริการสอบเทียบเครื่องมือวัดให้กับผู้ประกอบการทั้งภาครัฐและเอกชน มีเครื่องมือวัดที่สามารถสอบกลับทางมาตรวิทยาไปยังหน่วยมาตรฐานสากล (SI unit) และมีระดับความแม่นยำของเครื่องมือที่สามารถตรวจวัดค่าความดันของห้องความดันลบ รวมถึงภาวะแวดล้อมในห้องผู้ป่วย ดำเนินการทดสอบ ดังนี้ 1. การวัดอัตราการไหลของอากาศที่ไหลผ่านพื้นที่ช่องระบายอากาศโดยใช้เครื่องมือวัดความเร็วลม (Air Velocity Meter) เพื่อหาอัตราการไหลเวียนของอากาศภายในห้องที่ทราบปริมาตร 2. การวัดค่าความดันอากาศภายในห้องเทียบกับความดันภายนอก (Differential Pressure) 3.การวัดอุณหภูมิ (Temperature) และ 4. ความชื้นสัมพัทธ์ (Relative humidity)



ศูนย์พัฒนาและวิเคราะห์สมบัติของวัสดุ มีภารกิจให้บริการทดสอบ ตรวจสอบ ตรวจประเมินและที่ปรึกษาทางวิศวกรรม ให้กับผู้ประกอบการทั้งภาครัฐและเอกชน ได้ดำเนินการตรวจวัดการรั่วไหล (leak test) ของอนุภาคออกจากห้องความดันลบ เพื่อประเมินประสิทธิภาพการกรองอนุภาคของระบบ HEPA filter ของห้องความดันลบแต่ละห้อง
“...ผลการทดสอบของทั้ง 3 หน่วยงานในสังกัดของ วว. พบว่า ห้องความดันลบของโรงพยาบาลศิริราชผ่านเกณฑ์การใช้งานได้ตามวัตถุประสงค์ นับเป็นการปฏิบัติงานที่เป็นรูปธรรมของ วว. อีกวาระหนึ่งในการร่วมเป็นหน่วยงานทดสอบด้านวิทยาศาสตร์ เทคโนโลยีและนวัตกรรม โดยเฉพาะจากสถานการณ์การแพร่ระบาดของเชื้อโควิด-19 ในปัจจุบัน ซึ่งจะสร้างความเชื่อมั่นในความปลอดภัยของพี่น้องประชาชนได้...” ผู้ว่าการ วว. กล่าว




อนึ่ง ห้องแยกผู้ป่วยแพร่เชื้อทางอากาศ เป็นห้องพักสำหรับผู้ป่วยแบบแยกเดี่ยว ที่มีการควบคุมคุณภาพอากาศเพื่อป้องกันการติดเชื้อทางอากาศภายในสถานพยาบาล หรือพื้นที่ที่ต้องการการควบคุม โดยมีแนวทางการควบคุม เช่น การควบคุมความดันระหว่างพื้นที่ให้ความดันอากาศภายในห้องผู้ป่วยต่ำกว่าภายนอก ส่งผลให้อากาศภายในห้องผู้ป่วยไม่ไหลออกไปภายนอก ป้องกันการแพร่กระจายเชื้อไปสู่บริเวณอื่นๆ รวมถึงการวัดอัตราการไหลเวียนของอากาศเพื่อให้มั่นใจว่ามีการถ่ายเทของอากาศที่เหมาะสม ไม่มีการสะสมของเชื้อโรค นอกจากนี้การวัดอุณหภูมิ ความชื้นภายในห้องผู้ป่วยเพื่อหาสภาวะที่เหมาะสม ไม่กระทบกับสุขภาพของผู้ป่วยและสามารถควบคุมการเจริญเติบโตของเชื้อโรคได้ รวมทั้งอากาศที่ไหลออกจากห้องจะต้องผ่านการกรองอากาศที่มีประสิทธิภาพสูง รวมถึงเจือจางและฆ่าเชื้อในอากาศก่อนปล่อยออกสู่ภายนอก
สอบถามรายละเอียดเพิ่มเติมและขอรับบริการด้านวิทยาศาสตร์ เทคโนโลยีและนวัตกรรม ของ วว. ได้ที่ ศูนย์ทดสอบและมาตรวิทยา วว. โทร. 0 2323 1672-80 โทรสาร 0 2323 9165 อีเมล mtc@tistr.or.th
![]()
กระทรวงการอุดมศึกษา วิทยาศาสตร์ วิจัยและนวัตกรรม (อว.)
เป็นหน่วยงานของรัฐที่จัดตั้งขึ้นเพื่อขับเคลื่อนการอุดมศึกษาไทย วิทยาศาสตร์ วิจัยและนวัตกรรม ไปสู่มาตรฐานในระดับสากล และเพิ่มอันดับความสามารถการแข่งขันในระดับนานาชาติอย่างยั่งยืน ไม่ได้มีวัตถุประสงค์เพื่อแสวงหากำไร หากท่านพบว่ามีข้อมูลใดๆ ที่ละเมิดทรัพย์สินทางปัญญาปรากฏอยู่ในเว็บไซต์นี้ โปรดแจ้งให้ทราบ เพื่อดำเนินการแก้ปัญหาดังกล่าวโดยเร็วที่สุดต่อไป
© 2020 Ministry of Higher Education, Science, Research and Innovation. ALL RIGHTS RESERVED.